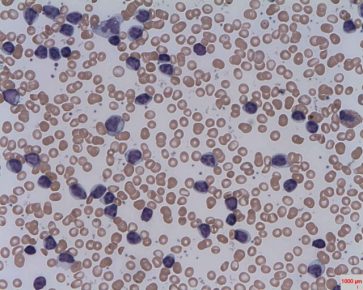

Visando Tóquio 2020, CBG anuncia nove ginastas para compor a Seleção

Nesta segunda-feira, a Confederação Brasileira de Ginástica (CBG) anunciou nove ginastas que irão compor a Seleção Brasileira da modalidade para o ciclo dos Jogos Olímpicos de 2020, que serão realizados em Tóquio. A CBG baseou as escolhas em desempenho em competições, avaliações médicas, físicas e técnicas. Até o momento, nove ginastas foram selecionados, sendo quatro […]
Recordista, Ana Marcela Cunha vence Capri-Napoli sem dificuldade

A maratonista Ana Marcela Cunha venceu, neste domingo, a prova Capri-Napoli de 36km. Representante da Unisanta, a nadadora brasileira conseguiu levar a melhor, já que tem certa proximidade com o percurso oficial de 36 km, porém, por conta do mau tempo da região italiana, o trajeto foi reduzido. A largada estava prevista para às 10h […]
Romário diz que poderia desbancar Messi e CR7 na Bola de Ouro

Romário sempre foi bastante contundente e sincero dando entrevista. Desta vez, em conversa com o El País, não foi diferente: o ‘Baixinho’, como é conhecido, afirmou que poderia desbancar Messi e Cristiano Ronaldo, caso jogasse nos dias atuais, e conquistar a Bola de Ouro. “Com certeza [poderia desbancar]. Apesar de todo respeito que tenho por Messi […]
Vitamina C leva à morte células que causam câncer no sangue
Injeções de altas doses de vitamina C podem ajudar no combate ao câncer de sangue, que inclui diferentes tipos de leucemia. Em experimentos realizados com camundongos, o nutriente se mostrou capaz de induzir o funcionamento do gene tet methylcytosine dioxygenase (TET2), responsável por forçar o desenvolvimento de células tronco em células sanguíneas maduras, que acabam […]
Maduro reclama de cinco países europeus por suas opiniões sobre opositora

O governo do presidente da Venezuela, Nicolás Maduro, entregou nesta segunda-feira (4) notas de protestos formais a diplomatas da Alemanha, Espanha, França, Itália e Reino Unido por suas opiniões sobre a proibição de saída do país imposta à opositora Lilian Tintori. “Tivemos que fazer esta convocação urgente dada a intromissão destes embaixadores e dos seus […]
Brasil tem superávit de energia pela primeira vez em 77 anos, segundo ministério

Pela primeira vez em quase 80 anos, em 2017 o Brasil deverá ter superávit de energia, segundo o Boletim Mensal de Energia, documento elaborado pela Secretaria de Planejamento e Desenvolvimento Energético do Ministério de Minas e Energia (MME), divulgado hoje (4). Esse é o melhor resultado desde 1940, ano inicial de disponibilidade de estatísticas globais […]
Pesquisa do CNJ revela que custo mensal de um juiz em 2016 foi de R$ 47,7 mil

Uma pesquisa divulgada pelo Conselho Nacional de Justiça (CNJ) revela que o custo mensal de um juiz no país foi de R$ 47,7 mil, em 2016. Os números foram divulgados hoje (4) pela presidente do Supremo Tribunal Federal (STF) e do conselho, ministra Cármen Lúcia. O gasto do orçamento do Judiciário com pessoal ficou em […]
Veja lista dos filmes do Brasil que irão tentar uma vaga no Oscar 2018

O Ministério da Cultura divulgou hoje (4) os 23 filmes brasileiros que irão disputar uma vaga entre os indicados ao prêmio de Melhor Filme em Língua Estrangeira na 90ª edição do Oscar, em março de 2018. O número de inscritos supera os do ano passado, quando 16 longas se inscreveram. Pela primeira vez, as inscrições […]
SUS terá medicamento para tratamento de convulsões em pacientes com microcefalia

O Sistema Único de Saúde (SUS) incorporou a oferta do medicamento Levetiracetam para o tratamento de convulsões em pacientes com microcefalia. O governo publicou na edição de hoje (4) do Diário Oficial da União a portaria que regulamenta a oferta do fármaco na rede pública de saúde. O prazo máximo para que o medicamento esteja disponível no […]
Material genético de ossadas de presos políticos será analisado no exterior

As primeiras amostras de material genético das ossadas encontradas no cemitério de Perus, em São Paulo, em 1990, serão enviadas ainda este mês para análise de DNA em um laboratório internacional. A informação foi confirmada à Agência Brasil por Javier Amadeo, representante da Universidade Federal de São Paulo (Unifesp) no Comitê Gestor do Grupo de Trabalho Perus. […]
Microplásticos ameaçam 529 espécies da fauna marinha em todo o mundo

Centenas de espécies da fauna marinha, como peixes, moluscos e outras, estão sendo ameaças pela ingestão do lixo que se acumula no mar em forma de microplásticos, sem que até o momento se saiba a fundo suas causas e consequências. Os últimos estudos apontam que até 529 espécies selvagens já foram afetadas pelos resíduos, um […]
Turista brasileiro morre durante protesto de taxistas em aeroporto no Chile

Um turista brasileiro de 65 anos morreu nesta segunda-feira (4) a caminho do aeroporto de Santiago, no Chile, durante um protesto realizado por taxistas, segundo a agência Reuters. O homem desmaiou e teve uma parada cardiorrespiratória, informou a polícia. Os taxistas protestavam contra o crescimento de aplicativos de viagens como o Uber e Cabify e […]
Petrobras faz novo reajuste e gasolina já sobe mais de 10% em setembro

A Petrobras anunciou nesta segunda-feira (4) uma nova elevação nos preços da gasolina em suas refinarias, que passam a acumular alta de mais de 10% em poucos dias de setembro. O aumento acontece após o furacão Harvey fechar refinarias nos Estados Unidos e levar a uma disparada nos valores de referência do combustível na semana […]
Garota de 19 anos morre após ser esfaqueada em Santa Bárbara d’Oeste

A jovem de 19 anos Bruna Rodrigues Gusmão Dessordi morreu após ser esfaqueada na noite deste domingo (3) em Santa Bárbara d’Oeste (SP). O suspeito de matá-la, um homem de 25 anos, se entregou, admitiu o crime e mostrou onde deixou o corpo da vítima. Segundo o pai e um amigo da vítima, Bruna chegou […]
Acidente entre três carros e caminhão deixa mortos na Rodovia Comandante João Ribeiro de Barros

Um acidente envolvendo três veículos e um caminhão deixou duas pessoas mortas no domingo (3), na Rodovia Comandante João Ribeiro de Barros (SP-294), próximo ao município de Herculândia (SP). De acordo com a Polícia Rodoviária, o motorista que dirigia o carro com placas de Herculândia bateu na lateral de outro veículo, com placas de Marília […]
Motorista morre em acidente entre três veículos na rodovia SP-101

Uma pessoa morreu em um acidente envolvendo três veículos na manhã desta segunda-feira (4) na Rodovia Campinas-Monte Mor (SP-101), no trecho de Elias Fausto (SP). Segundo informações da Polícia Rodoviária, o motorista do carro estava no trevo de acesso à cidade e quando foi fazer o retorno para Campinas (SP), foi atingido pela van e […]
Casal fica ferido após acidente com aeronave na zona rural de Itaí

Um casal ficou gravemente ferido após se envolver em um acidente com uma aeronave experimental em uma pista de pouso e decolagem próximo à vicinal Mário Covas, na zona rural de Itaí (SP). Segundo a polícia, o acidente aconteceu no domingo (3), mas os policiais foram informados nesta segunda-feira (4). De acordo com o delegado […]
Cachorra resgatada coberta de óleo se recupera e ganha novo lar em Tupã

Cerca de um mês e meio depois de ser retirada das ruas, Lola, a cachorra que foi resgatada coberta de óleo e com sarna por todo o corpo em um terreno próximo a Unesp de Tupã (SP), passou por uma transformação completa com o tratamento veterinário, banhos e muito carinho. Inclusive, foi até adotada pela família […]
Botucatu: Cantor Daniel se apresenta no Largo da Catedral no dia 16

A população de Botucatu recebeu um grande presente neste mês de setembro. É o show do cantor Daniel, no próximo dia 16, no Largo da Catedral. A realização é da Federação das Indústrias do Estado de São Paulo, Fiesp, através do SESI e do Senai, em parceria com a Prefeitura. O show faz parte do […]
Botucatu: Confira a programação cultural e os cursos da Feira do Verde 2017

Neste feriado prolongado tem atração para toda a família na 23ª Feira do Verde de Botucatu. Entre os dias 7 a 10 de setembro, o Parque Municipal “Joaquim Amaral Amando de Barros” terá exposições, atrações culturais, praça de alimentação, e outras atividades. A Feira é uma oportunidade importante para que os expositores realizem negócios, aumentem […]


